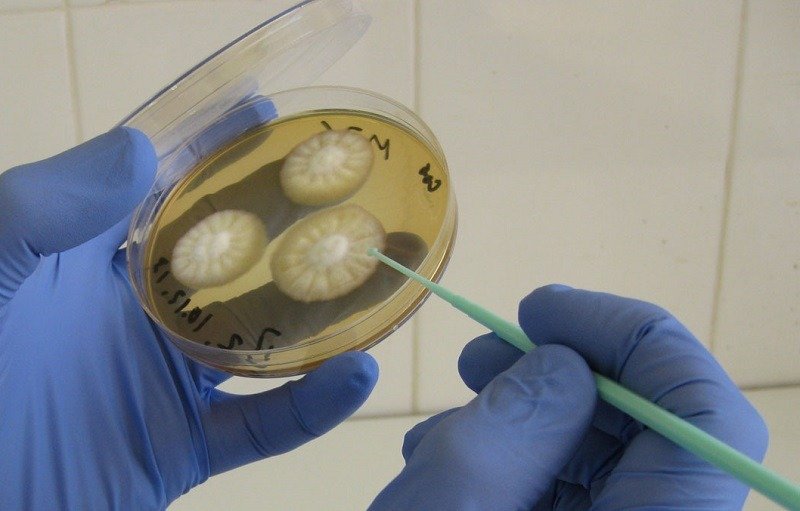
Посев на среду Сабуро - надежный метод диагностики

Среди грибковых заболеваний актиномикоз у человека протекает тяжелее и часто переключается на внутренние органы. Возбудитель недуга в природе распространен, но случаи инфицирования редки. Обычно актиномицеты не вызывают заболевания, а поселяются на слизистых оболочках в виде сапрофитной флоры. Если инфекция охватывает слизистые оболочки глаз, то высока вероятность необратимых изменений. При отсутствии адекватной терапии актиномикоза могут развиться слепота и нарушения в работе головного мозга.
Причины возникновения актиномикоза
Возбудитель актиномикоза имеет необычную структуру. Речь идет о лучистых грибах, которые занимают промежуточное положение между бактериями и истинными грибами. Они имеют нитевидную структуру, но содержат нуклеоид. Из-за особенностей строения клеток осложняется терапия актиномикоза. Препараты с противогрибковой активностью оказываются неэффективны в отношении актиномицетов.
Лучистые грибы размножаются спорами, обитают в почве, на зерновых культурах. Именно поэтому чаще всего носителями актиномикоза являются лица, работающие в сельскохозяйственной отрасли. В организме человека грибы поселяются в среде условно-патогенной флоры. Экзогенный путь инфицирования подразумевает заражение через внешний источник – вдыхание пыли со спорами, проглатывание частиц, находящихся на растениях.
Эндогенное заражение актиномикозом предполагает присутствие грибка в организме человека. Но он неактивен до тех пор, пока не снизится иммунная защита. Это происходит из-за авитаминоза, переохлаждения, длительного воздействия стрессовых факторов. Актиномикоз у человека обостряется и по другим причинам:
- травмирование кожи и слизистых;
- предшествующие простуды;
- гнойные заболевания глаз;
- воспалительные заболевания полости рта;
- сахарный диабет;
- бронхиальная астма;
- онкологические заболевания.
Возбудитель актиномикоза поражает одинаково как женщин, так и мужчин, но у последних актиномикоз развивается в 2 раза чаще. Причины такого поведения грибка не установлены. Предполагается, что это связано с условиями труда мужчин и повышенными нагрузками. Ослабление иммунитета наблюдается у женщин в период беременности, но актиномикоз не прогрессирует, если отсутствуют провоцирующие факторы. Глазной актиномикоз у человека может развиться после операции на глазах. Что касается возрастного диапазона, то в группу риска входят лица в возрасте 21-40 лет.
Актиномикоз глаз является редким, но серьезным заболеванием, вызванным бактериями рода Actinomyces. Врачи отмечают, что основными факторами риска являются травмы глаз, а также ослабленный иммунитет. Симптомы могут варьироваться от покраснения и отека до образования абсцессов, что требует немедленного вмешательства.
Лечение актиномикоза глаз включает в себя антибиотикотерапию, часто с использованием пенициллиновых препаратов, которые эффективны против Actinomyces. В некоторых случаях может потребоваться хирургическое вмешательство для удаления инфицированных тканей. Врачи подчеркивают важность ранней диагностики и комплексного подхода к лечению, чтобы избежать серьезных осложнений, таких как потеря зрения. Регулярные осмотры и внимание к симптомам могут значительно повысить шансы на успешное выздоровление.
https://youtube.com/watch?v=bGtG6jRjZ90
Симптоматика актиномикоза
Недуг не прогрессирует даже после того, как возбудитель актиномикоза попал в организм. Инкубационный период может достигать нескольких лет. В ряде случаев носитель инфекции не догадывается о том, что в его организме проживает лучистый грибок.
Глазной актиномикоз у человека – довольно редкое явление. Чаще возникает челюстно-лицевой актиномикоз. С момента активизации грибка на пораженном органе образуются гранулемы. Они накапливают гной и являются источником инфекции. При разрыве полости содержимое попадает в ближние ткани и происходит повторное инфицирование. В этом случае симптомы актиномикоза подразумевают:
- сильное воспаление слизистой;
- образование абсцессов на веках;
- формирование незаживающих свищей.
Актиномикоз у человека практически никогда не протекает самостоятельно. Сразу же после вскрытия гранулем происходит инфицирование бактериальной флорой, преимущественно кокковой группы. Одновременно наблюдаются аллергические реакции, которые возникают из-за сбоя в организме. Актиномикоз протекает тяжело и периодически обостряется. Если грибок охватил ткани глаз, то в скором времени в патологический процесс могут быть вовлечены и другие органы. Подкожные инфильтраты распространяются по лицу и охватывают глазницы, гортань, миндалины, язык.
При поражении актиномикозом глазниц наблюдается гнойное выделение, ресницы слипаются, ухудшается зрение. Заболевание опасно тем, что провоцирует осложнения и само по себе лечится сложно.
Диагностика актиномикоза
Если актиномикоз у человека достиг критической стадии, то сложностей с выявлением заболевания не возникает. На начальном периоде актиномикоз может походить на воспалительные заболевания глаз. Только микробиологическая диагностика позволяет точно определить возбудителя и своевременно начать медикаментозную терапию. Материал для исследования берут со слизистой глазного яблока. Если имеются гнойные образования, то для исследования лучше всего подойдет содержимое гранулем.
Микробиология является обязательной процедурой при подозрении на инфекционные заболевания глаз. Мазки с конъюнктивы могут оказаться не слишком информативными ввиду наличия иных возбудителей на слизистой. Обычно назначают посев на среду Сабуро. Это исследование позволит выявить именно грибковую природу заболевания. Результаты можно увидеть на 2-3 день.
Если на коже лица имеются шарообразные гнойники, то лучше извлекать биологический материал из них. Делают это посредством подкожной пункции.
Сложности с исследованием содержимого гранулем объясняются тем, что биологический материал быстро окисляется. Желательно, чтобы забор материала и диагностика актиномикоза осуществлялись в одном месте.
При подозрении на распространение грибка во внутренние органы проводят КТ с контрастированием. Следует дифференцировать актиномикоз от гнойников иной природы, флегмоны глазницы, абсцессов, воспалительных заболеваний глаз.
Актиномикоз глаз — редкое, но серьезное заболевание, вызываемое бактериями рода Actinomyces. Люди, столкнувшиеся с этой проблемой, часто описывают свои ощущения как болезненные и дискомфортные. Симптомы могут включать покраснение, отек и гнойные выделения из глаза. Многие пациенты отмечают, что первоначально не придавали значения легкому дискомфорту, что привело к запущенной форме болезни. Важно понимать, что ранняя диагностика играет ключевую роль в успешном лечении. Врачи обычно назначают антибиотики, которые помогают справиться с инфекцией. Однако в некоторых случаях может потребоваться хирургическое вмешательство для удаления пораженных тканей. Люди, прошедшие курс лечения, подчеркивают важность регулярных осмотров у офтальмолога и соблюдения рекомендаций врача для предотвращения рецидивов.
https://youtube.com/watch?v=oe47DCJyeto
Лечение актиномикоза
Консервативная терапия актиномикоза не исключает хирургическое лечение. Вскрытие гнойников необходимо во избежание их разрыва с последующим истечением содержимого во внутренние органы. Медикаментозная терапия направлена на купирование инфекции, укрепление иммунитета, повышение общей реактивности организма. Физиопроцедуры и методы нетрадиционной медицины позволяют ускорить процессы восстановления и противодействуют обострению недуга.
Лечение актиномикоза обязано быть комплексным. Стабильный результат не может гарантировать ни одна из приведенных лечебных техник. Только все вместе они способны купировать болезнь на ранней стадии и предотвратить развитие необратимых последствий.
Медикаментозная терапия
Актиномикоз у человека успешно лечится с помощью антибиотиков. Назначаются препараты пенициллинового и тетрациклинового ряда. Они подавляют активность лучистого грибка и препятствуют его размножению. Лечение актиномикоза антибиотиками длится от 1 до 3 месяцев. Рекомендована инъекционная терапия. Препараты предлагаются курсами и чередуются для повышения эффективности.
Если в ассоциации с актиномицетами выявлены анаэробные бактерии, то назначают препараты-карбапенемы. Они подавляют активность как аэробной, так и анаэробной микрофлоры. Параллельно используются антигрибковые средства, которые подбираются индивидуально.
Иммунотерапия является необходимым элементом консервативного лечения. Традиционно назначают актинолизат, который действует следующим образом:
- активизирует фагоцитоз;
- усиливает выработку антител;
- противодействует вторичной инфекции;
- препятствует вовлечению в патологический процесс здоровых тканей.
Параллельно используются витаминно-минеральные комплексы, антисептические и противовоспалительные средства для наружной обработки, детоксикационные препараты. Снять негативные проявления медикаментозной терапии и воздействия грибка позволяют антигистаминные средства. Обычно используют «Тавегил», «Цетрин» и др.
https://youtube.com/watch?v=Z-PLA3FOisw
Физиопроцедуры
Лечение физическими факторами позволяет купировать актиномикоз и усилить эффективность основной терапии. Хорошие результаты дает воздействие ультрафиолета с электрофорезом актинолизата. Метод активизирует иммунобиологические силы, снижает вирулентность грибковой инфекции. Комплексное лечение позволяет купировать грибковую инфекцию и форсировать процессы восстановления.
Актиномикоз у человека успешно лечится следующими физиопроцедурами:
- фонофорез с йодом – обладает антисептическим действием, улучшает трофические процессы и подавляет размножение грибка, способствует рассасыванию инфильтратов;
- УВЧ-терапия – стимулирует рост здоровых клеток, препятствует рецидивам, улучшает местный иммунитет;
- новокаин-электрофорез – блокирует болезненность, проводится в зону воспаления. Курс лечения составляет 20-25 процедур;
- флюктуоризация – показана при гнойной форме с вовлечением в патологический процесс близлежащих тканей. Стимулирует регенераторные процессы, улучшает отхождение гноя. Курс лечения составляет 8-12 процедур.
При длительном течении недуга назначают слаботепловую УВЧ-терапию и общее УФ-облучение. Это делается с целью активизировать иммунный отклик и поднять общий иммунитет. Если недуг будет прогрессировать, то пострадают жизненно важные органы и системы организма.
Народная медицина
Если актиномикоз у человека не затухает, то методы народной медицины усилят основную терапию. Недуг относится к крайне опасным, поэтому нетрадиционная медицина бессильна при актиномикозе. Но с ее помощью удастся быстрее восстановиться и избежать нежелательных последствий.
Во-первых, следует скорректировать рацион. Потенциально вредными продуктами считаются углеводистая пища, дрожжи, сыры с плесенью. При грибковой инфекции особую пользу принесут продукты с высоким содержанием йода. К ним относят морскую рыбу, йодированную соль, редис, спаржевую фасоль, морскую капусту.
Во вторых, актиномикоз у человека купируется проверенными препаратами на основе фитосредств. Среди наиболее популярных рецептов:
- смешать почки березы, мелиссу, зверобой и хвощ полевой в равном соотношении. Заваривать кипятком из расчета 1 ст. л. смеси на 1 стакан воды. Настоять, процедить и принимать в течение 2-3 мес. для дезоксидации организма, повышения иммунитета и снятия воспалительных реакций;
- соединить листья бадана, водяного трилистника, мяты из расчета 2:2:1. Крепким отваром (2 ст. л. с горкой на 500 мл воды) промывают глаза, а также принимают внутрь в течение квартала. В составе отвара содержатся йод, дубильные вещества, сапонины и другие полезные элементы, которые останавливают рост грибка;
- настойку левзеи разводят в дозировке 40 капель на четверть стакана воды и принимают ежедневно для повешения общей устойчивости организма инфекциям;
- если образовались свищи на поверхности лица, то их обрабатывают спиртовой настойкой чеснока (медицинский спирт и измельченные зубчики в равном соотношении). Перед применением настойку разводят дистиллированной водой. Область глаз не трогают.
Прогноз и осложнения актиномикоза
Если актиномикоз у человека продолжает прогрессировать, то наступают необратимые последствия. Наиболее опасным осложнением считается поражение ЦНС. В этом случае процент летальных исходов составляет 50%.
При легком течении заболевания прогноз благоприятный. Лицевые актиномикозы в начальной стадии успешно купируются. Иммунитет к заболеванию практически не формируется. Поэтому после завершения лечебного курса проводят поддерживающую терапию, акцентируя внимание на иммуностимулирующих препаратах.
Обострение актиномикоза возможно в случае развития стоматологических недугов, ЛОР-заболеваний, бронхита, конъюнктивита. Важно вовремя купировать простудные проявления, не допуская их перехода в хроническую форму.
Если в прошлом имел место актиномикоз у человека (независимо от локализации поражения), то для профилактики рецидивов проводят усиленную иммунотерапию. При повреждении целостности кожи антисептическая обработка ссадин является обязательной. Если рана начинает нагнаиваться, то сразу обращаются за помощью к инфекционисту.
Осложненный глазной актиномикоз у человека легко переходит в торакальную либо абдоминальную форму. В этом случае повышается угроза для жизни. С вовлечением в патологический процесс внутренних органов эффективность терапии снижается, ухудшается уровень жизни больного. Повышается риск истинно бактериального инфицирования и развития воспалительных процессов смешанного характера. Организм становится восприимчив к любым инфекциям. Особенно тяжело протекает актиномикоз при иммунодефицитных состояниях.
Даже после излечения не исключен повторный актиномикоз у человека. В связи с этим пациента наблюдают в течение двух лет. В этот период исключают сельскохозяйственные работы, своевременно проводят санацию любых очагов инфекции, осуществляют адекватный уход за слизистыми оболочками. При поражении глазниц наблюдение у офтальмолога обязательно. Даже при успешном лечении актиномикоза не исключены негативные последствия для зрения и тканей глаза. Лица, перенесшие актиномикоз глазниц, подвержены воспалительным недугам офтальмологического характера.
Вопрос-ответ
Какова этиология актиномикоза?
Актиномикоз — это хроническое инфекционное заболевание, вызываемое актиномицетами (лучистыми грибами). Эти бактерии чаще размножаются в почве, участвуя в разложении гумуса. Некоторые формы актиномицетов не патогенны для человека, а другие являются условно патогенной флорой, выделяемой из полости рта и кишечника.
Что такое актиномицетная инфекция глаза?
Актиномикоз чаще всего проявляется в виде шейно-лицевой инфекции, составляя приблизительно 50% всех случаев актиномикоза. Actinomyces может вызывать пресептальный целлюлит, орбитальный целлюлит, каналикулит, конъюнктивит, кератит и эндофтальмит. Также сообщалось о случаях вызывания протокового воспаления слезной железы.
Наиболее часто поражаются Актиномикозом области?
Основные положения: актиномикоз, как правило, проявляется несколькими небольшими смежными абсцессами со свищевыми ходами, с гнойным отделяемым. Инфекционный процесс обычно распространяется на шею и лицо, легкие, органы брюшной полости и малого таза.
Советы
СОВЕТ №1
Обратите внимание на симптомы: если вы заметили покраснение, отек или выделения из глаза, не откладывайте визит к врачу. Раннее обращение поможет предотвратить осложнения и улучшить прогноз лечения.
СОВЕТ №2
Следите за гигиеной: соблюдение чистоты рук и глаз поможет снизить риск заражения актиномикозом. Избегайте контакта с потенциально загрязненными предметами и не трите глаза грязными руками.
СОВЕТ №3
Не занимайтесь самолечением: при подозрении на актиномикоз глаз важно обратиться к специалисту для получения точного диагноза и назначения адекватного лечения. Использование неподходящих препаратов может усугубить ситуацию.
СОВЕТ №4
Следите за состоянием иммунной системы: поддержание общего здоровья и укрепление иммунитета помогут организму лучше справляться с инфекциями, включая актиномикоз. Включите в рацион витамины и минералы, занимайтесь физической активностью и избегайте стрессов.